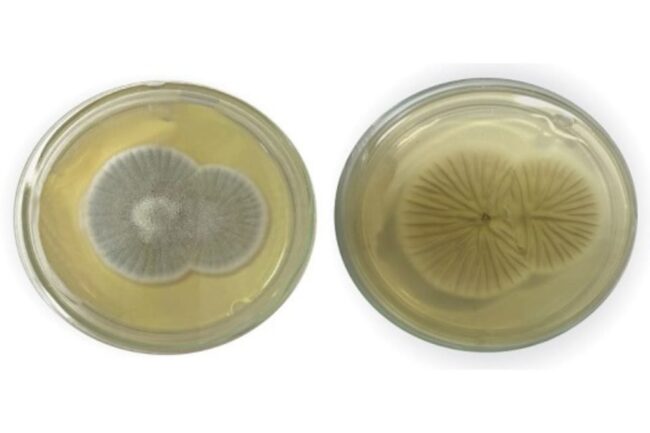

Séries do streaming viram salvação para falta de conteúdo da TV Aberta
Após reinarem por anos a fio, as emissoras de televisão se viram em uma encruzilhada quando os streamings passaram a explodir no Brasil e no mundo. Se antes era necessário esperar um filme ou uma série sair da televisão para ser acompanhada em outras plataformas, tal qual aconteceu com inúmeros sucessos, desta vez estamos diante…